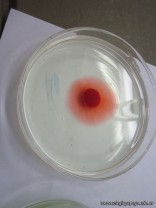
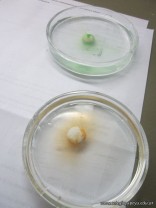
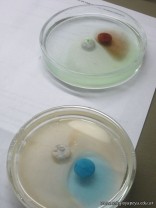

Los alumnos de 4to año con orientación en Ciencias Naturales, en el espacio curricular Química I, procedieron a separar componentes de diversas mezclas naturales y artificiales mediante cromatografía,.Para separar los componentes de pigmentos vegetales (clorofila y carotenos), utilizaron cromatografía en columna. Para separar los componentes de diversas tintas utilizaron cromatografía en papel y mediante cromatografía en columna tambien procedieron a separar los componentes de colorantes de alimentos.
Noticia anterior/siguiente:

¡Interesantísima experiencia!
Se los ve concentradísimos con el trabajo en el laboratorio, a continuar así, y seguir experimentando, es una manera efectiva de llegar al conocimiento.